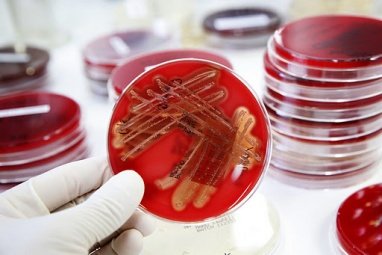

Vyriausybė pritarė Sveikatos apsaugos ministerijos pateiktam Administracinių teisės pažeidimų kodekso straipsnių pakeitimo ir papildymo įstatymo projektui.
Jo tikslas – užkirsti kelią pacientams nebaudžiamai kaip vaistus siūlyti neveiksmingus preparatus arba skatinti nesuderinamų vaistų vartojimą. Projekte nustatyta atsakomybė už veiklos su vaistais (vaistiniais preparatais) bei medicininės paskirties produktais sąlygų pažeidimus. Įstatymo projektas teikiamas svarstyti Seimui.
Dabar yra numatyta administracinė atsakomybė už neteisėtą vertimąsi farmacine veikla. Tačiau ši sąvoka yra palyginti siaura, ji neapima specifinių, su medicininės paskirties produktais susijusių veiklų, tokių kaip reklama, informacijos skleidimas visuomenėje ir pan. Pagal naują įstatymo projektą, nustatoma administracinė atsakomybė, drausminanti veiklą vykdančius subjektus, kurie sudaro nesąžiningos konkurencijos sąlygas, skleidžia klaidinančią informaciją bei reklamą, iškraipydami rinką ir pažeisdami kitų sąžiningų rinkos dalyvių teises bei interesus.
Projekte nustatyta administracinė atsakomybė už visuomenės sveikatą nepalankiai veikiančius vaistų (vaistinių preparatų) ir medicininės paskirties produktų reklamos ir informacijos apie juos skleidimo pažeidimus. Sugriežtinta atsakomybė už neregistruotų ar registruotų, receptinių ar nereceptinių vaistų, medicininės paskirties produktų, narkotinių ir psichotropinių vaistų ar preparatų reklamą.